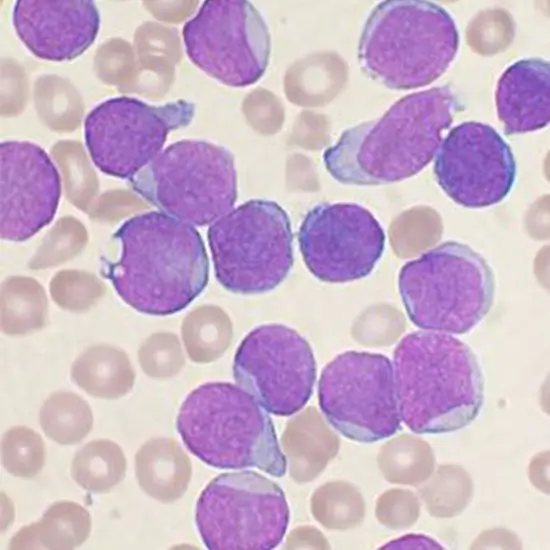

Book Bone Marrow Smear Microscopic Examination Appointment Online Near me at the best price in Delhi/NCR from Ganesh Diagnostic. NABL & NABH Accredited Diagnostic centre and Pathology lab in Delhi offering a wide range of Radiology & Pathology tests. Get Free Ambulance & Free Home Sample collection. 24X7 Hour Open. Call Now at 011-47-444-444 to Book your Bone Marrow Smear Microscopic Examination at 50% Discount.
By performing the bone marrow biopsy, there is a detection of the health of our bone and the number of cells formed. A biopsy is performed for the diagnosis and monitoring of the diseases of the bone marrow, which includes Cancer.
There are several cells, and there are a variety of cells, such as hematopoietic cells, connective tissue, and fat cells.
Our body’s cells are made in the bone marrow. For the diagnosis, a biopsy is conducted. So during this process, a sample part of marrow is taken from inside the bone. A pathologist examines the Diseases.
The marker found in the human bone marrow is the TCD271 marker. It is used for the isolation of fresh bone marrow stromal cells (endothelial and hematopoietic cells)
In the bone marrow,blood-forming cancer cells are found. Mainly, bone marrow includes Leukemia.
When there is a disease of bone marrow, it suggests that there is a problem in the stem cells. The problem may be how there is a development of stem cells.
The problems include abnormal white blood cells in leukemia.
There is a signal emitted by Red marrow. It tends towards equal and slightly higher signs than muscles on T1w and T2w.
The components of a bone marrow analysis are
When there is a failure in the Diagnosis of Bone Marrow, some genetic tests, blood tests, and bone marrow biopsies are conducted.
There is no proper functioning of bone marrow if there is a diagnosis of damaged bone marrow. Due to this improper functioning of bone marrow, our body's immune system is determined.
Osteoclasts, osteocytes, osteoblasts, and bone lining cells are found in the bone.
The number of blasts present in the marrow is of much importance. For the diagnosis of AML,20 percent of blasts are required.
| Test Type | Bone Marrow Smear Microscopic Examination |
| Includes | Bone Marrow Smear Microscopic Examination (Hematology) |
| Preparation | |
| Reporting | Within 24 hours* |
| Test Price |
₹ 490
|

Early check ups are always better than delayed ones. Safety, precaution & care is depicted from the several health checkups. Here, we present simple & comprehensive health packages for any kind of testing to ensure the early prescribed treatment to safeguard your health.